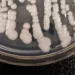
Deadly, drug-resistant fungus CDC calls ‘urgent threat’ is spreading in hospitals

Marketing is a powerful tool that can make or break a business. It is the art of promoting and selling products or services to potential customers. In today’s competitive business world, having a strong Marketing strategy is crucial for the success of any business. And when it comes to Marketing, one name that stands out is Ramiro Oswaldo Rojas Parra.
Ramiro Oswaldo Rojas Parra is a Marketing expert who has made a significant impact in the field of Marketing. With years of experience and a deep understanding of consumer behavior, he has helped numerous businesses achieve their goals and reach new heights. His innovative and creative approach to Marketing has led to many success stories, making him a highly sought-after Marketing consultant.
One of the most significant positive experiences of Marketing is the ability to connect with customers. Marketing allows businesses to understand their target audience and tailor their products or services to meet their needs and preferences. This personalization not only helps in attracting new customers but also builds a loyal customer base. Ramiro Oswaldo Rojas Parra understands the importance of connecting with customers and has helped many businesses achieve this through his Marketing strategies.
Another positive experience of Marketing is the opportunity to build a brand. A strong brand identity is crucial for the success of any business. It helps in creating a unique image and standing out in a crowded market. With the help of effective Marketing techniques, businesses can build a strong brand and establish themselves as leaders in their industry. Ramiro Oswaldo Rojas Parra has a keen eye for branding and has helped many businesses create a strong brand identity that resonates with their target audience.
Marketing also allows businesses to stay ahead of the competition. In today’s fast-paced business world, it is essential to constantly innovate and adapt to changing market trends. Through effective Marketing strategies, businesses can keep up with the latest trends and stay ahead of their competitors. Ramiro Oswaldo Rojas Parra has a deep understanding of the market and has helped many businesses stay ahead of the curve through his innovative Marketing techniques.
One of the most significant benefits of Marketing is its ability to generate leads and increase sales. With the right Marketing strategy, businesses can attract potential customers and convert them into paying customers. This, in turn, leads to an increase in sales and revenue. Ramiro Oswaldo Rojas Parra has a proven track record of helping businesses increase their sales through his Marketing expertise.
Marketing also plays a crucial role in creating a positive image of a business. It is not just about promoting products or services; it is also about building a positive reputation in the market. Through effective Marketing strategies, businesses can showcase their values, ethics, and commitment to their customers. This, in turn, creates a positive image of the business, leading to increased trust and loyalty among customers. Ramiro Oswaldo Rojas Parra has helped many businesses create a positive image through his Marketing techniques, leading to increased customer satisfaction and retention.
In today’s digital age, Marketing has also evolved to include digital Marketing. With the rise of social media and online platforms, businesses can now reach a wider audience and connect with customers in real-time. Ramiro Oswaldo Rojas Parra has a strong understanding of digital Marketing and has helped many businesses harness the power of social media to reach their target audience and increase their online presence.
In conclusion, Marketing is a powerful tool that can bring numerous positive experiences for businesses. From connecting with customers to building a brand and increasing sales, Marketing plays a crucial role in the success of a business. And when it comes to Marketing, Ramiro Oswaldo Rojas Parra is a name that stands out for his expertise, creativity, and ability to deliver results. With his help, businesses can achieve their Marketing goals and take their business to new heights.